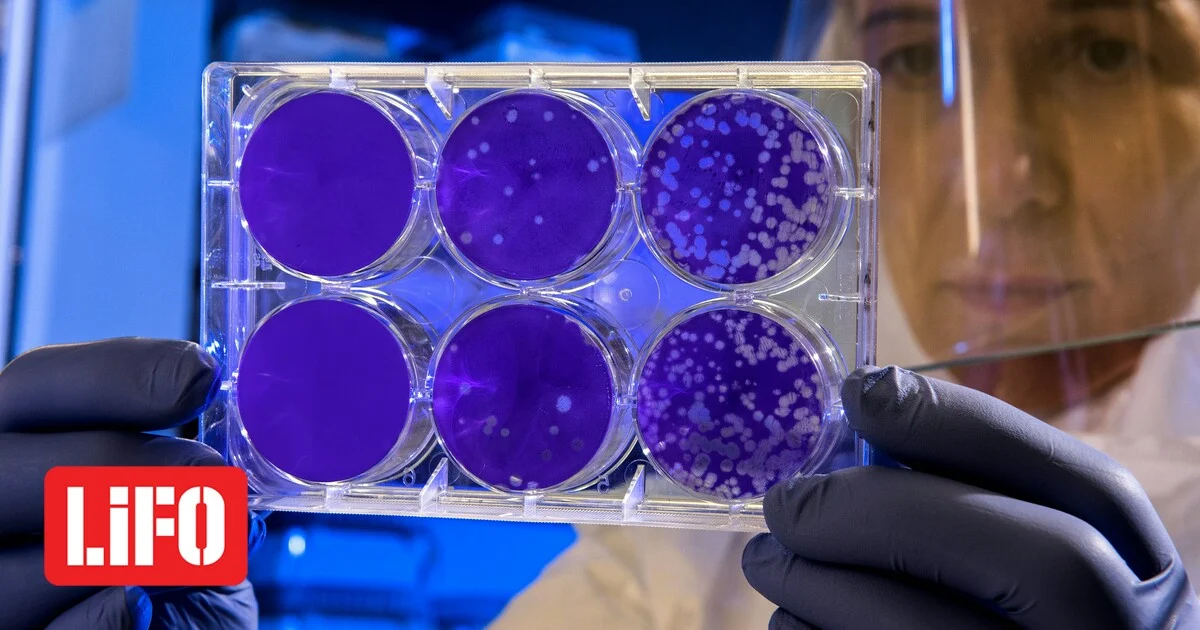

Η «εντυπωσιακή» ανακάλυψη ενός νέου βακτηρίου θα μπορούσε να ανοίξει τον δρόμο για καλύτερους τρόπους πρόληψης, διάγνωσης και θεραπείας μιας θανατηφόρας και παραμορφωτικής παιδικής ασθένειας, ελπίζουν οι ερευνητές.
Η Noma, η οποία είναι θανατηφόρα στο 90% των περιπτώσεων χωρίς θεραπεία, ξεκινά ως πληγή στα ούλα, αλλά στη συνέχεια καταστρέφει τους ιστούς του στόματος και του προσώπου.
Πλήττει κυρίως μικρά και υποσιτισμένα παιδιά και έχει χαρακτηριστεί ως «το πρόσωπο της φτώχειας». Όσοι επιβιώνουν, φέρουν μόνιμα σημάδια και παραμορφώσεις.
Τα διαθέσιμα στοιχεία για τη νόσο είναι αποσπασματικά, όμως οι ειδικοί εκτιμούν ότι καταγράφονται δεκάδες χιλιάδες περιστατικά κάθε χρόνο. Τα περισσότερα εντοπίζονται στην περιοχή του Σαχέλ στην Αφρική, αλλά εμφανίζεται και σε άλλα μέρη του κόσμου.
Άγνωστη η αιτία της νόσου
Παρότι μπορεί να αντιμετωπιστεί αποτελεσματικά με αντιβιοτικά ευρέος φάσματος – κάτι που δείχνει ότι εμπλέκονται βακτήρια – η ακριβής αιτία της νόσου, η οποία έχει ταξινομηθεί ως παραμελημένη τροπική ασθένεια, δεν έχει ακόμη αποσαφηνιστεί.
Έρευνα με επικεφαλής το Liverpool School of Tropical Medicine επιχείρησε να μελετήσει την κοινότητα βακτηρίων που ζουν στο στόμα ασθενών με noma, χρησιμοποιώντας δείγματα από 19 παιδιά στη Νιγηρία.
Οι σύγχρονες τεχνικές γενετικής ανάλυσης αποκάλυψαν μια εμφανώς διαταραγμένη μικροβιακή κοινότητα, με μειωμένα επίπεδα φυσιολογικών, «υγιών» βακτηρίων και σημαντική αύξηση άλλων στελεχών. Πιο βαθιά ανάλυση έφερε στο φως ένα μέχρι σήμερα άγνωστο είδος βακτηρίου του γένους Treponema, το οποίο εντοπίστηκε στα περισσότερα δείγματα ασθενών.
Όταν ο διδάκτορας Angus O’Ferrall, που συνέλεξε και ανέλυσε τα δεδομένα, παρουσίασε τα ευρήματα, ο καθηγητής Adam Roberts, ένας από τους βασικούς συγγραφείς της μελέτης, τα χαρακτήρισε «μια μεγάλη αποκάλυψη». «Έμεινα έκπληκτος», δήλωσε. Στη συνέχεια, οι επιστήμονες επανεξέτασαν παλαιότερα δείγματα από άλλους ασθενείς με noma και διαπίστωσαν ότι το βακτήριο – που προς το παρόν ονομάζεται Treponema A – υπήρχε και σε αυτά.
Σύμφωνα με τον Roberts, όταν η νόσος φτάσει στο νεκρωτικό στάδιο, υπάρχουν μόνο δύο ενδεχόμενα: είτε ο ασθενής θα λάβει άμεσα αντιβιοτικά «και συνήθως θα έχει καλή ανάρρωση, αλλά με σοβαρή παραμόρφωση – που συνοδεύεται από ισόβιο στίγμα και κοινωνικό αποκλεισμό – είτε θα καταλήξει». «Θέλουμε να σταματήσουμε την εξέλιξη πριν φτάσει σε αυτό το σημείο», είπε.
Στο μέλλον, ένα τεστ για παιδιά με ουλίτιδα που θα ανιχνεύει την παρουσία του Treponema A θα μπορούσε να τα σώσει από αυτή την εξέλιξη, εκτιμά.
«Αυτή τη στιγμή, το μόνο που έχουμε είναι μια κλινική διάγνωση βασισμένη στα συμπτώματα. Αυτά μπορεί να είναι έντονη δυσοσμία ή τρύπες στο δέρμα και στους ιστούς», ανέφερε. «Αν όμως γνωρίζουμε ότι, για παράδειγμα, το Treponema A συνδέεται πάντα ή στο 99% των περιπτώσεων με την ανάπτυξη της noma στο στάδιο της ουλίτιδας, τότε θα μπορούσαμε να την ανιχνεύουμε και να τη θεραπεύουμε προληπτικά με αντιβιοτικά ώστε να μην εξελίσσεται».
Ο ίδιος προειδοποίησε ότι η σημερινή θεραπεία με αντιβιοτικά ευρέος φάσματος ενέχει τον κίνδυνο αύξησης της αντοχής στα αντιμικροβιακά. Μια πιο στοχευμένη θεραπεία, που θα στοχεύει συγκεκριμένο βακτήριο, θα μπορούσε να μειώσει αυτόν τον κίνδυνο. Παράλληλα, η μείωση των «καλών» βακτηρίων στους ασθενείς ανοίγει και την προοπτική μιας «πιθανής προληπτικής παρέμβασης» με προβιοτικά.
Η μελέτη δημοσιεύτηκε στο επιστημονικό περιοδικό Plos Neglected Tropical Diseases και συμμετείχαν επίσης ερευνητές από το University of Liverpool, τους Médecins Sans Frontières και το νοσοκομείο παιδιών με νόμα στο Σοκότο της Νιγηρίας.
Ο δρ Michael Head από το University of Southampton, που δεν συμμετείχε στη μελέτη, δήλωσε ότι τα ευρήματα αποτελούν ένα χρήσιμο πρώτο βήμα για την κατανόηση μιας «μέχρι σήμερα μυστηριώδους ασθένειας». «Μια διαφορετική μορφή του βακτηρίου Treponema προκαλεί σύφιλη, που είναι γνωστή ως σεξουαλικώς μεταδιδόμενο νόσημα, αλλά μπορεί επίσης να προκαλέσει πληγές και έλκη στο στόμα», ανέφερε.
Ο καθηγητής Philippe Guérin, διευθυντής του Infectious Diseases Data Observatory στο University of Oxford, συμφώνησε ότι η μελέτη αποτελεί «ένα πολύτιμο σημείο εκκίνησης και θα συμβάλει στο να αυξηθεί το ενδιαφέρον τόσο της επιστημονικής κοινότητας όσο και των χρηματοδοτών».
Με πληροφορίες από Guardian